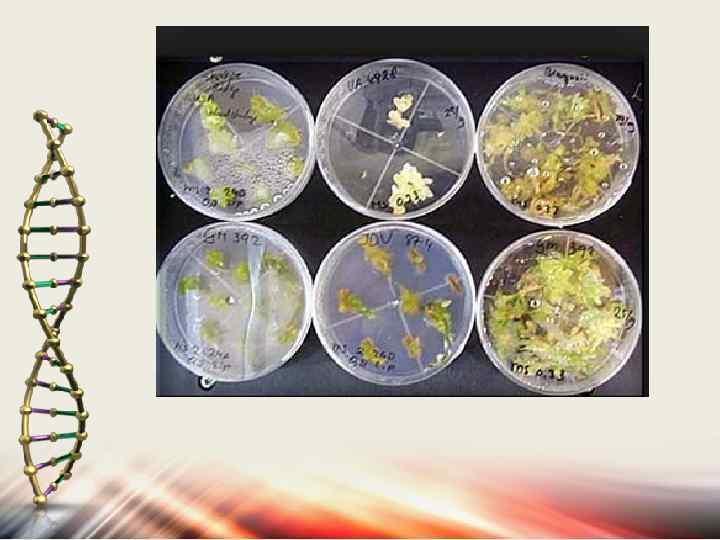

Биотехнология_лекция 4.pptx
- Количество слайдов: 34

1 2 3

Биотехнология и сельское хозяйство 1. Биотехнология в растениеводстве. 2. Культивирование клеток высших растений.

1. 2. 3. 4. Для успешного культивирования изолированных клеток и тканей растений необходимо соблюдать определенные физические условия выращивания: Температурный фактор. Освещение. Влажность. Условия аэрации и состав газов.

Растения культивируют в камерах фитотрона. Фитотрон – это (от фито-… и греч. thronos – местопребывание, средоточие), помещение для выращивания растений в искусственно регулируемых условиях. В фитотроне изучают влияние на растения температуры, освещенности, влажности и др. факторов. В фитотроне можно получать несколько урожаев в год и ускорять селекционный процесс.



Температура в камерах фитотрона обычно : 26 ± 1 °С. Для культуры тканей тропических растений: 29 -30 °С. В случае индукции морфогенеза: 18 – 20 °С

Условия освещения также оказывает влияние на рост изолированных клеток, тканей и органов растений. Большинство каллусных тканей не нуждается в свете, так как они не имеют хлоропластов и питаются гетеротрофно.

Большинство каллусных тканей получают в темноте и при рассеянном свете. Освещенность может влиять на метаболизм каллусных клеток. Культивирование изолированных меристем и их размножение происходит на свету. На культуру ткани и ее физиологические особенности влияет качество света. Свет разной длины волны регулирует процессы первичного и вторичного метаболизма. Также необходимо учитывать фотопериод.

Влажность в культуральной комнате должна составлять 60 -70%. Более сухой воздух способствует усыханию питательной среды в пробирках и колбах, если они закрыты ватными пробками, изменению ее концентрации и нарушению условий культивирования.

Важное значение имеют условия аэрации и состав газов (газовая фаза). Условия газового режима в культуре клеток и тканей остаются малоизученными. Но известно, что в зависимости от газовой смеси резко изменяется интенсивность клеточного деления и процессы дифференцировки и формообразования.


Образование и рост каллусной культуры регулируется ауксинами и цитокининами.

Каллус может образовываться и на изолированных кусочках ткани (эксплантах) in vitro. Каллусную ткань in vitro можно получить практически из любой живой ткани растения. Выбор экспланта в значительной степени определяется целями исследования.

Выбранный эксплант должен находиться в подходящем биологическом состоянии. Молодые ткани более пригодны для получения каллусной культуры, чем зрелые. Лучшими эксплантами также являются ткани, ответственные за пролиферацию. Проращивание простерилизованных семян в асептических условиях часто дает наиболее пригодный материал для получения каллусов.

Образование каллусов зависит от размеров экспланта. Для каждого вида растений существует минимальный критический размер экспланта. При его уменьшении невозможно индуцировать образование каллуса. Он сильно варьирует у разных видов.

Важна ориентация эксплантов в пространстве при переносе их на питательную среду. Кончики корней легко образуют каллус, если они помещены на агар горизонтально. Сегменты стебля лучше образуют каллус, если их поместить вертикально, одним из концов поместив в агар.

Для образования каллусной ткани in vitro клетки экспланта должны дедифференцироваться, т. е. утратить специфические характеристики исходной ткани.

Для образования каллуса в питательной среде должны присутствовать ауксины и цитокинины. Наиболее удобная модель для изучения механизма дедифференциации и каллусообразования – культура сердцевинной паренхимы стебля табака, так как для нее существует строгая зависимость индукции деления и каллусообразования от присутствия ауксина и цитокинина.

Установлено, что в растительной клетке существует двойной гормональный контроль деления: ауксин необходим для перехода специализированной клетки из пресинтетической фазы в синтетическую, а цитокинин – для прохождения постсинтетической фазы, митоза и цитокинеза.

Каллусная ткань, выращиваемая поверхностным способом на агаре, представляет собой аморфную массу тонкостенных паренхимных клеток, не имеющих строго определенной анатомической структуры.

Каллусные ткани делят по таким морфологическим признакам, как цвет, консистенция, характер поверхности, а также по интенсивности роста и способности к зеленению

Цвет каллусной ткани может быть беловатым, желтоватым, бурым, коричневым, полностью или частично пигментированным хлорофиллом или антоцианами. Темно-коричневая окраска часто возникает при старении каллусных клеток и связана с накоплением в них фенолов.

В зависимости от источника получения различают гомогенные и гетерогенные каллусы. В зависимости от консистенции каллусные ткани бывают рыхлыми, среднеплотными и плотными.

В случае получения первичного каллуса при оптимально подобранной среде часть эксплантов обычно за 3 -8 недель образует каллусы в количестве, достаточном для пересадки. Для того, чтобы не произошло старения, утраты способности к делению и отмирания каллусных клеток, полученный каллус переносят на питательную среду. Эту операцию называют пассированием.

Оптимальный размер пересаживаемого каллуса зависит от вида растения. Каллусные ткани можно выращивать неопределенно долго, периодически пересаживая их на свежую питательную среду. Удачно полученные линии каллусных культур требуют регулярной пересадки примерно через каждые 4 недели.

Суспензионные культуры Это культуры, выращиваемые в жидкой питательной среде во взвешенном состоянии и состоящие из отдельных клеток и их агрегатов.

Преимущества суспензионной культуры § Более широкие возможности для изучения влияния экзогенных факторов на метаболизм и рост клеточных популяций. § Надежное длительное поддержание линии вследствие простоты процессов субкультивирования. § Удобство для проведения биохимических и молекулярно-биологических исследований, а также быстрой регенерации растений.

Для получения суспензионной культуры чаще всего используют каллусную ткань рыхлого типа, которая легко фрагментируется на отдельные клетки и небольшие агрегаты при помещении ее в перемешиваемую жидкую среду. Для этого снижают концентрацию цитокининов и увеличивают концентрацию ауксинов.

Клеточные суспензии обычно требуют регулярного и более частого субкультивирования, чем каллусные культуры. Часть суспензионной культуры, используемая для пересадки на свежую среду, называется инокулюм. Для каждой линии культуры клеток существует минимальный размер инокулюма, при уменьшении размера которого культура не растет.

Для получения суспензионной культуры , проявляющей высокий уровень клеточной диссоциации, чаще всего прибегают к контролированию состава питательной среды. Ауксины оказывают положительное влияние на процессы диссоциации клеток, а цитокинины тормозят их.

СПАСИБО ЗА ВНИМАНИЕ!
Биотехнология_лекция 4.pptx